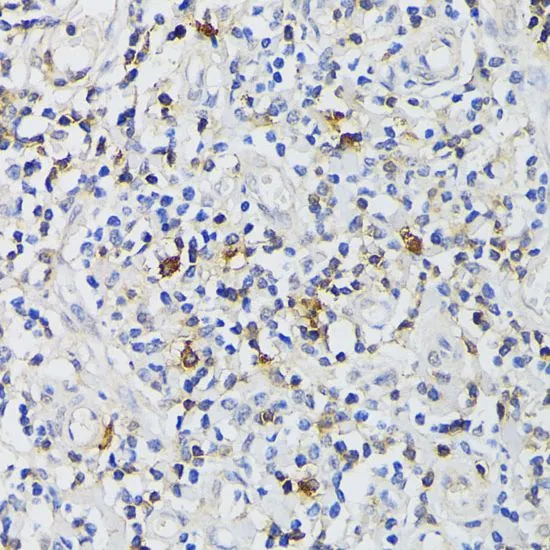

WB analysis of various sample lysates using GTX53910 CD3 epsilon antibody. Dilution : 1:1000 Loading : 25microg per lane
CD3 epsilon antibody
GTX53910
ApplicationsWestern Blot, ImmunoHistoChemistry, ImmunoHistoChemistry Paraffin
Product group Antibodies
TargetCD3E
Overview
- SupplierGeneTex
- Product NameCD3 epsilon antibody
- Delivery Days Customer7
- Application Supplier NoteWB: 1:500 - 1:2000. IHC-P: 1:50 - 1:200. *Optimal dilutions/concentrations should be determined by the researcher.Not tested in other applications.
- ApplicationsWestern Blot, ImmunoHistoChemistry, ImmunoHistoChemistry Paraffin
- CertificationResearch Use Only
- ClonalityPolyclonal
- ConjugateUnconjugated
- Gene ID916
- Target nameCD3E
- Target descriptionCD3 epsilon subunit of T-cell receptor complex
- Target synonymsCD3epsilon, IMD18, T3E, TCRE, T-cell surface glycoprotein CD3 epsilon chain, CD3-epsilon, CD3e antigen, epsilon polypeptide (TiT3 complex), CD3e molecule, epsilon (CD3-TCR complex), T-cell antigen receptor complex, epsilon subunit of T3, T-cell surface antigen T3/Leu-4 epsilon chain
- HostRabbit
- IsotypeIgG
- Protein IDP07766
- Protein NameT-cell surface glycoprotein CD3 epsilon chain
- Scientific DescriptionThe protein encoded by this gene is the CD3-epsilon polypeptide, which together with CD3-gamma, -delta and -zeta, and the T-cell receptor alpha/beta and gamma/delta heterodimers, forms the T-cell receptor-CD3 complex. This complex plays an important role in coupling antigen recognition to several intracellular signal-transduction pathways. The genes encoding the epsilon, gamma and delta polypeptides are located in the same cluster on chromosome 11. The epsilon polypeptide plays an essential role in T-cell development. Defects in this gene cause immunodeficiency. This gene has also been linked to a susceptibility to type I diabetes in women. [provided by RefSeq, Jul 2008]
- Storage Instruction-20°C or -80°C,2°C to 8°C
- UNSPSC12352203

![FACS analysis of Jurkat cells using GTX17861 CD3 epsilon antibody [C3e/1931]. Blue : Primary antibody Red : Isotype control](https://www.genetex.com/upload/website/prouct_img/normal/GTX17861/GTX17861_20200115_FACS_1486_w_23060620_753.webp)
![FACS analysis of Jurkat cells using GTX17864 CD3 epsilon antibody [C3e/2478]. Blue : Primary antibody Red : Isotype control](https://www.genetex.com/upload/website/prouct_img/normal/GTX17864/GTX17864_20200115_FACS_1480_w_23060620_284.webp)

![FACS analysis of human PBMC cells using GTX10869 CD3 epsilon antibody [CA-3]. Blue : Primary antibody Green : Isotype control Red : Cell only control Antibody amount : 1microg/1x10? cells for 30 min at 20oC](https://www.genetex.com/upload/website/prouct_img/normal/GTX10869/GTX10869_20190815_FACS_w_23060120_666.webp)